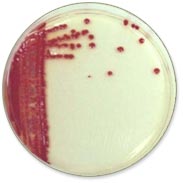
Placeholder image

Lecture 14 - Special Topics
See Lecture Schedule for Delivery Date
Learning Objectives
- Examine the chemistry of selenium in inorganic and organic molecules.
- Understand the role of seleno-amino acids in the expression of selenium toxicity in plant and animal systems.
- Examine chronic selenium toxicosis (selenosis).
- Understand the role of selenium in aquatic bird teratogenesis.
- Describe the biogechemical cycle of selenium.
- Analyze environmental Se case studies.
- Examine the regulatory and scientific issues involved in Se risk assessment.
- Explore the occurrence of Arsenic in drinking water.
- Describe the US As regulatory changes.
- Describe the clinical pathology of arsenicosis.
- Examine the arsenic in drinking water public health emergency in Bangladesh.
Listen online or Download here
Advanced Reading
- Technical fact sheet on drinking water selenium.
- ATSDR Public Health Statement: selenium NIEHS
- ATSDR Public Health Statement: arsenic
- USEPA - As in drinking water
- West Bengal and Bangladesh Arsenic Crisis Information Center (site familiarization)
- Chronic Arsenic Poisoning: History, Study and Remediation (Harvard U.) (site familiarization)
Resources
Keywords
- Selenite
- Selenate
- Selenide
- Biogeochemical cycling
- Seleno-amino acid
- Aquatic biota criteria
- SRB - sulfate reducing bacteria
- SeRB - selenium reducing bacteria
- Selenosis
- Arsenicosis
- Tubewell
- Keratosis
- BAT - best available technology
Suggested Reading

ETox is licensed under a Creative Commons Attribution-NonCommercial-NoDerivatives 4.0 International License.